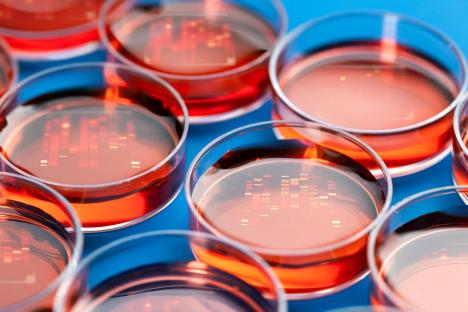
eksperiment.jpg

ZELENO SVETLO ZA NOVI EKSPERIMENT: Naučnici će pokušati da vrate mrtve u život

Američke kompanije dobile su dozvolu da pokušaju da ožive mrtve. U inicijalnim testovima koristiće se niz različitih tehnika na 20 subjekata koji su doživeli moždanu smrt.
U prvoj fazi testiranja eksperimenti biće vršeni na 20 subjekata da bi se utvrdilo da li pokazuju bilo kakve znake regeneracije ili preokretanja procesa moždane smrti.
Istraživači se nadaju da će uspeti da održe u životu moždano mrtve pacijente tako što će podstaći obnavljanje moždanog tkiva, što trenutno nije moguće izvesti.
Jednom kada mozak odumre ljudi se više ne mogu vratiti u život, bez obzira na to što njihova tela i dalje rastu, zarastaju, vare hranu, proizvode fekalije i hormone, seksualno sazrevaju, mogu da imaju povišenu temperaturu, donesu dete na svet...
Iako se mozak ljudske vrste ne obnavlja, ova karakteristika može se uočiti kod nekih vrsta riba i vodozemaca.
Kompanije “Bioquark” i “Revita Life Sciences” nadaju se da će isti efekat uspeti da proizvedu i kod ljudi i ističu da bi nova tehnika jednog dana mogla da bude od velike koristi obolelima od Alchajmerove i Parkinsonove bolesti.
Ovi eksperimenti biće izvršeni u Indiji.
(Independent)